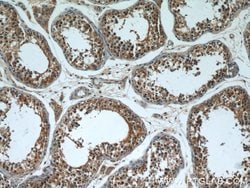
VDAC3 Rabbit anti-Human, Mouse, Rat, Polyclonal, Proteintech 20 &mu;L;

missing translation for 'onlineSavingsMsg'
Learn More
Learn More
VDAC3 Rabbit anti-Human, Mouse, Rat, Polyclonal, Proteintech
Rabbit Polyclonal Antibody
Brand: Proteintech 55260-1-AP-20UL
This item is not returnable.
View return policy
Description
This antibody is specific to VDAC3.
The Voltage-Dependent Anion Channel (VDAC) of the outer mitochondrial membrane, a small abundant protein found in all eukaryotic kingdoms, forms a voltage-gated pore when incorporated into planar lipid bilayers. VDAC is also the site of binding of the metabolic enzymes hexokinase and glycerol kinase to the mitochondrion in what may be a significant metabolic regulatory interaction. VDAC3 is involved specifically in translocation of adenine nucleotides through the outer membrane.Specifications
| VDAC3 | |
| Polyclonal | |
| Unconjugated | |
| VDAC3 | |
| HD VDAC3, hVDAC3, VDAC 3, VDAC3 | |
| Rabbit | |
| Antigen Affinity Chromatography | |
| RUO | |
| 22335, 7419, 83532 | |
| -20°C | |
| Liquid |
| Western Blot, Immunoprecipitation, Immunohistochemistry (Paraffin) | |
| 0.37 mg/mL | |
| PBS with 50% glycerol and 0.02% sodium azide; pH 7.3 | |
| Q60931, Q9R1Z0, Q9Y277 | |
| VDAC3 | |
| Peptide | |
| 20 μL | |
| Primary | |
| Mouse, Rat, Human | |
| Antibody | |
| IgG |
Product Content Correction
Your input is important to us. Please complete this form to provide feedback related to the content on this product.
Product Title
Spot an opportunity for improvement?Share a Content Correction